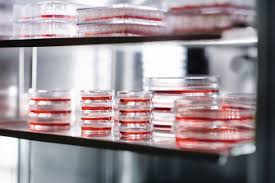
二氧化碳培養(yǎng)箱做培養(yǎng)時注意培養(yǎng)箱濕度、防止箱內(nèi)污染做好箱內(nèi)消毒

做培養(yǎng)時注意培養(yǎng)箱濕度
做培養(yǎng)時注意培養(yǎng)箱濕度
箱內(nèi)濕度對于培養(yǎng)工作來說是一項非常重要然而又經(jīng)常被忽略的因素。因為飽和濕度環(huán)境可以避免培養(yǎng)液中二氧化碳逃逸 , 培養(yǎng)液中 pH 值穩(wěn)定 , 有利于細(xì)胞生長 , 足夠的濕度水平并且要有足夠快的濕度恢復(fù)速度 (如在開關(guān)門后)才能保證不會由于過度干燥而導(dǎo)致培養(yǎng)失敗。
所以
二氧化碳培養(yǎng)箱使用過程中, 在箱內(nèi)托盤中放一定量的滅菌水(3/2**全盤), 使箱內(nèi)成為飽和濕度環(huán)境。如使用者忘記補(bǔ)加水 , 使培養(yǎng)細(xì)胞處于低濕度甚**干熱環(huán)境中, 培養(yǎng)液二氧化碳?xì)怏w易揮發(fā), 液體 pH 值升高, 影響細(xì)胞生長, 在工作中要力求避免此問題發(fā)生。
樣本多時, 箱內(nèi)分區(qū)存放 , 培養(yǎng)物用筐或瓷盤存放 , 這樣存取快速 , 縮短開門時間, 減少箱內(nèi)氣體和濕度變化, 節(jié)省氣體 , 穩(wěn)定了細(xì)胞生長環(huán)境。
防止二氧化碳培養(yǎng)箱污染做好箱內(nèi)消毒
CO2培養(yǎng)箱污染是導(dǎo)致細(xì)胞培養(yǎng)失敗的一個主要因素, 所以要減少和防止污染的發(fā)生 , 主要途徑是盡量減少微生物可以生長的區(qū)域和表面, 采取消毒措施。
例如, 針對箱內(nèi)濕熱環(huán)境易滋生細(xì)菌等問題, 我們采用在1000mL 水中加2 mL 新潔爾滅液, 定期用酒精和紫外線消毒箱內(nèi)空氣 , 培養(yǎng)物酒精擦拭入箱內(nèi), 盤里的水**少要一周換一次 , 控制污染 , 可以維持適應(yīng)的蒸發(fā)作用, 減少箱內(nèi)微生物滋生速度。為了
培養(yǎng)箱免受污染并且保證儀器箱體內(nèi)的生物清潔性, 有些
CO2培養(yǎng)箱設(shè)計了自動排除污染裝置來有效防止污染的產(chǎn)生。
目前有多種消毒滅菌方式, 如帶有紫外消毒功能的 CO2
培養(yǎng)箱。還有的設(shè)計生產(chǎn)了 HEPA 過濾器能過濾
培養(yǎng)箱內(nèi)空氣, 可過濾除去 99.97 %的 0.3 μm 以上的顆粒 , 此外, 還有設(shè)計了能使箱內(nèi)達(dá)到高溫濕熱的環(huán)境從而殺死污染微生物 , 達(dá)到消毒滅菌目的的培養(yǎng)箱。
做培養(yǎng)時注意培養(yǎng)箱濕度
做培養(yǎng)時注意培養(yǎng)箱濕度